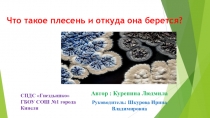
Презентация исследовательской деятельности. На Тему :  Что такое плесень и откуда она берется?

- Главная
- Разное
- Образование
- Спорт
- Естествознание
- Природоведение
- Религиоведение
- Французский язык
- Черчение
- Английский язык
- Астрономия
- Алгебра
- Биология
- География
- Геометрия
- Детские презентации
- Информатика
- История
- Литература
- Математика
- Музыка
- МХК
- Немецкий язык
- ОБЖ
- Обществознание
- Окружающий мир
- Педагогика
- Русский язык
- Технология
- Физика
- Философия
- Химия
- Шаблоны, фоны, картинки для презентаций
- Экология
- Экономика
Презентации без категории
Здесь, Вы можете изучить и скачать презентации из раздела Разное. Презентацию на заданную тему можно скачать внизу страницы, поделившись ссылкой в социальных сетях.